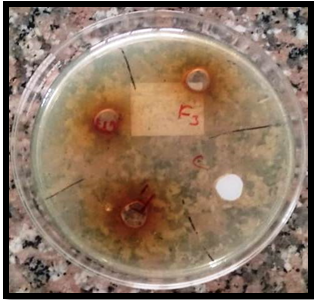
Antimicrobial activity of standard Ampicillin and prepared solution (F-1, F-2 and F-3) against Streptococcus aureus.

- Visibility 581 Views
- Downloads 108 Downloads
- Permissions
- DOI 10.18231/j.ijpca.2024.022
-
CrossMark
- Citation
Formulation of mouth rinse from natural plant's leaf extract and evaluation of antibacterial activity
Abstract
Herbal liquid formulations are the preparation for oral health related issues like toothache, swelling, redness, bacterial or fungal infection in mouth, tooth decay, bleeding gums, weakened gums, etc. Such preparation also improves gums strength, removing bad breath and give fresh feel during good start of the day. Dentists generally use such preparations as antimicrobials before or after oral surgery to sanitize the surface of affected gums and teeth to avoid further contamination. Herbs like Tulsi, Clove, Mint, Ginger etc., are generally used either alone or in combination in herbal mouth-wash preparations which also render antibacterial activities. The other herbs like Eucalyptus and Liquorices have been reported to possess antibacterial, anti-oxidant, aromatic, anti- inflammatory and sweetening properties. In the present work, the research continues with formulation and evaluation of a herbal mouth rinse by using a combination of selected herbal extracts of Tulsi, Bael, Eucalyptus leaves and Liquorices rhizome for their antimicrobial activity against S. aureus using agar well diffusion plate technique. It was found that the formulated herbal mouth rinse or preparations gave satisfactory results in controlling the microorganism. Different physicochemical tests of prepared preparations were performed to figure out their pH, phase separation, homogeneity and scent.,
Introduction
Dental diseases are the most common type of non-communicable disease. Many numerous bacterial species that are found to be present in human saliva which can cause a variety of dental issues, most notably dental caries and gingivitis. It was found that due to consequence of the continuous influx of nutrients from saliva, food intake, warm temperatures, and moisture the, microorganisms develop quickly and build dental plaque in the mouth area. Plaque makes the gum line and chewing area more vulnerable to decay. Unpleasant mouth odor is another problem associated with teeth caused by volatile sulfur compounds.[1] Dental floss, inter-dental cleaners, and chemotherapeutic items like mouthwash, dentifrices, and chewing gum are generally used to overcome oral problems. Mouth rinse or mouthwash is the most popularly used supplementary element in dental care. Mouth rinses can be used in either preventing or treating oral problems as they have anti-microbial, deodorizing, and refreshing effects.[2], [3] Dentists use mouthwash to avoid any infection in the oral cavity as they contain antibacterial agents. Streptococcus mutans and Candida albicans are mostly responsible microorganisms in oral diseases.[4], [5] The lips and hands serve as the pathogen's main reservoirs in the hospital setting which then spread to many different regions of the human body.[6] Currently, most of us use commercially available mouth rinse preparations, which contain several chemicals like chlorhexidine, sodium lauryl sulfate, methyl salicylate, benzalkonium chloride, hydrogen peroxide, etc. But it was found that there is most prevalent side effect in tooth staining. Natural products obtained from different sources like plants or herbs, animals and minerals play a significant role in the development of drugs[6], [7] and are the source of more than 25 % of modern medications. Medicinal herbs have been used to cure illnesses from a long time. The literature survey reveals that Tulsi extract is most commonly useful in treating periodontitis and rich in Vitamin C and zinc.[8], [9], [10] Herbs like Bael leaves have antibacterial properties and are believed to decrease bad oral odors and also possess anti-inflammatory, anti-oxidant and antibacterial properties.[11] Extract of herb like Eucalyptus is useful in gingivitis.[12], [13] The chemical constituents present in the herbs like liquorices have potential fruitful effects in oral diseases its mouthwash and are also effective in treatment of stomatitis, mouth ulcer.[14], [15] In view of importance of herbs in dental diseases and mentioned biological activities of pants like Tulsi, Bael, Eucalyptus and Liquorices herbs, herewith we formulate and evaluate new preparation or mouth rinse in which the extract of all mentioned herbs like Tulsi, Bael, Eucalyptus and Liquorices were incorporated.
Materials and Methods
In present research methodology; Extracts of leaves of various plants were used and Shadow Drying Technique was followed to get dried plant product.[7]
Collection: Leaves of Tulsi (Ocimum sanctum Linn), Bael (Aegle marmelos Linn) Euca-lyptus (Eucalyptus globules Labill) and stem of Liquorices (Glycyrrhiza glabra Linn) were randomly collected from mature plants. Specimens were authenticated at laboratories.
Extraction: Collected leaves of the selected mature plants were washing with sterile water in order to remove dust and dirt. The leaves were spread in container trays and kept at room temperature for 4- 5 days in the shade. Later the dried leaves were taken and pulverized with the help of a sterile mixer under a septic condition. The pulverized leaves were transferred to air-tight sterile container jars. Sterile distilled water (100 ml) was taken in four conical flasks and the pulverized leaves were weighed and suspended in distilled water under sterile conditions. The preparations were heated and sterilized at 40°C for 5-10 minutes and incubated at 37°C for 72h. After incubation the extracts were filtered and boiled vigorously to kill the bacterial spores to avoid contamination. The extracts after heating are ready to use for the formulation (F) of mouth rinse [Table 1].
Preparations: A measure quantity of each extract was taken in a mortal pestle and a small amount of water added to this mixture of all ingredients and then triturated and mixed properly in such way that the lump formation was avoided. The final volume was made with water and added salt solution for its preservative as well as flavoring effects. Formulated products were packed in well-closed sterile containers and evaluated for different formulation parameters.
Formulation Parameter: pH of the formulations was determined by using Digital pH meter kncp-ELICO-LI-120. A standard buffer solution was used for the purpose of calibrating the instrument. About 1 ml of mouth rinse was taken and dissolved in 50 ml of distilled water and its pH was recorded.

Microbial Activity
The streak plate method was implemented for evaluating the presence of microbial growth in the formulated mouth rinses. A control was also prepared in the same way. The plates were incubated by placing them in the incubator at 37°C for the duration of 24 hours. After completion of the incubation period, the plates were checked for microbial growth by comparing them with the control.
|
Sr. No |
Ingredients |
Actvity |
F-1 |
F-2 |
F-3 |
|
1. |
Tulsi Ocimum sanctum Linn |
Anti-bacteria Anti- inflammatory |
03ml |
04 ml |
05 ml |
|
2. |
Bael Aegel marmelos |
Anti-bacteria Anti- inflammatory |
04 ml |
05 ml |
06 ml |
|
3. |
Eucalyptus Eucalyptusglob ulus |
Anti-bacteria Anti- inflammatory |
03 ml |
03 ml |
03 ml |
|
4. |
Liquorice Glycyrrhiza glabra |
Anti- inflammatory and Sweetener |
04 ml |
03 ml |
04 ml |
|
5. |
Salt solution |
Preservative |
05 ml |
7.5 ml |
10 ml |
|
6. |
Distilled Water |
Vehicle |
29 ml |
23.5 ml |
18 ml |
|
7. |
Total Volume |
- |
50 ml |
50 ml |
50 ml |
|
Sr. No |
Staphylococcus aureus |
Zone of Inhibition (mm) |
||
|
20μl |
40μl |
60μl |
||
|
1. |
F-1 |
8 |
10 |
10 |
|
2. |
F-2 |
10 |
12 |
13 |
|
3. |
F-3 |
11 |
12 |
14 |
|
4 |
Control drug:- Ampicillin (50mg/ml) |
12 |
13 |
15 |
|
Sr. No |
Formulation Number |
Colour |
Odour |
Homogeneity |
pH |
|
1. |
F-1 |
Light brown |
Pleasant |
Good |
6.1 |
|
2. |
F-2 |
Light brown |
Pleasant |
Good |
6.3 |
|
3. |
F-3 |
Light brown |
Pleasant |
Good |
6.2 |
Antimicrobial activity
Evaluation of Mouth Rinse: The formulated mouth rinse was inoculated in the plates of agar media by streak plate method and a control was prepared by using Ampicillin as a standard antibiotic. In vitro, antibacterial activity was finished on isolated colonies of Streptococcus aureus. The agar well diffusion technique was adopted for determining the zone of inhibition and minimum inhibitory concentrations (MIC). The strains of Streptococcus aureus were inoculated in a pre- fabricated agar plate. When the plates were dried then three wells were drilled with the help of a 6 mm agar well cutter. Mouth rinse solutions in the concentration of 20 μl, 40 μl, and 60 μl were loaded in all the respective wells. The drug-loaded agar plates were kept undisturbed for the passive diffusion of herbal mouth rinses in to the agar culture medium and incubated at 37°C for 24 hours. Commercially available Antibiotic Ampicillin (50mg/ml) was used as the positive control. The zone of inhibition in mm was recorded for each plate and compared with the control.
Results and Discussion
Physical parameters like colour, odour and homogeneity were done by visual examination and pH was determined using a digital pH meter kncp-ELICO-LI-120.
Among the different formulations, the best formulation of mouth rinse is F-3. This mouth rinse was effective in combating oral bacteria. It is stable for long-term storage in terms of pH, color and odor. The formulation's pH was determined and found to be in the range of 6.1-6.3. The results of the pH range of the formulated mouth rinse are suitable for oral disorders [Table 2].
The formulations were free of microorganisms because any microbial growth was not observed in them. The antibacterial activity of different concentrations of mouth rinses was determined using the agar well diffusion method. The zone of inhibition results for Staphylococcus aureus was determined and found to be more than 8 mm which indicates better anti-microbial activity of these formulations [Figure 2] and [Table 3].
These results indicated that the herbal mouth rinse has considerable antibacterial action and that the new preparation can prevent bacterial development in the oral cavity. The association of oral microbial load on oral diseases in well-established, thus this herbal mouthwash helps in motivating good oral health.
Conclusion
In this study, the natural plants or herbs like Tulsi, Bael, Eucalyptus and Liquorices extracts were utilized to get alternate preparations or mouth rinse because of their reported antibacterial as well as anti - inflammatory properties. The zone of inhibition results indicated that this herbal mouth rinse was an effective plaque inhibitor. And thus, can render a promising formulation in periodontal diseases. Due to the above-cited results, the formulations can be used in conjunction with mechanical therapy to treat plaque-induced gingivitis and for other benefits like a feeling of freshness after use. A person can simply rinse his or her mouth with this herbal mouth rinse and avoid a wide range of oral health disorders. The results of the present study showed that herbal mouth rinse renders inhibitory effects on bacterial growth. The selected ingredient shows bacteriostatic or bactericidal effects.
Source of Funding
None.
Conflict of Interest
None.
References
- Yactayo- Alburquerque T, Alen- Méndez L, Azañedo D, Comandé D, Hernández- Vásquez A. Impact of oral diseases on oral health-related quality of life; A systematic review of studies conducted in Latin America and the Caribbean. PloS one. 2021;16(6):252578-252578. [Google Scholar]
- Aldhaher ZA. . Antimicrobial activity of different types of mouthwashes against Streptococcus mutans, Staphylococcus aureus and Candida albicans;; Bagh Coll Den. 2013;25:185-91. [Google Scholar]
- Bodake Ravina S, Archana B, B, Vaishnavi B, K, Prajwal V, et al. formulation and evaluation of Heerbal mouthwash. International Journal of Advanced Research in Science, Communication and Technology. ;2022(2):608-617. [Google Scholar]
- Lowy FD. Staphylococcus aureus infections. New England journal of medicine. 1998;339(8):520-532. [Google Scholar]
- Banu J, Gayathri V. Preparation of antibacterial herbal mouthwash against oral pathogens. Int. J. Curr. Microbial App. Sci. ;2016(11):205-205. [Google Scholar]
- Yadav A. Preparation and Evaluation of Herbal Mouthwash containing Psidiumguajava Leaf Extract. International Journal of Pharmaceutical Research and Development. ;2020(1):24-30. [Google Scholar]
- Abhishek D, Purohit *, Mishra MU, Vithika V, Gupta AK, Kshirsagar AS, et al. Liquorice mouth wash as treatment for mouth ulcer. International Journal of Pharmaceutical Research and Applications. 2022;7:720-728. [Google Scholar]
- Ramteke C, Chakrabarti T, Sarangi BK, Pandey RA. . Synthesis of silver nanoparticles from the aqueous extract of leaves of Ocimum Sanctum for enhanced antibacterial activity. 2013. [Google Scholar]
- Mondal S. Antimicrobial and Immuno-modulatory effects of Tulsi Thesis for degree of Doctor of Philosophy. All India Institute of Medical Sciences. 2010. [Google Scholar]
- Siva MP, Shanmugam KR, Shanmugam T, Venkata B, Ravi SG, Sathyavelu SS, et al. Ocimum sanctum: A review on the pharmacological properties. Int. J. Basic Clin. Pharmacol. 2016;5:558-565. [Google Scholar]
- Raghunathan D, Chaly PE. Antimicrobial Activity of Bael, Cinnamon and Neem Extracts Against Common Oral Microorganisms-An In- Vitro Comparative Study. Journal of Pharmaceutical Negative Results. 1962. [Google Scholar]
- Müller-Heupt LK, Vierengel N, Groß J, Opatz T, Deschner J, Von Loewenich FD. . Antimicrobial activity of Eucalyptus globulus, Azadirachta indica, Glycyrrhiza glabra, Rheum palmatum extracts and rhein against Porphyromonas gingivalis; Antibiotics. 2022;11:186-186. [Google Scholar]
- Suhani A, Shah. To formulate and evaluate herbal mouthwash. Journal of Pharmacognosy and Phytochemistry. ;2024(1):11-18. [Google Scholar]
- Malvania EA, Sharma AS, Sheth SA, Rathod S, Chovatia NR, Kachwala MS. In vitro analysis of licorice (glycyrrhiza glabra) root extract activity on streptococcus mutans in comparison to chlorhexidine and fluoride mouthwash. J Contemp Dent Pract. 2019;20(12):1389-1394. [Google Scholar]
- Samruddhi M, Jagdale HS, Nawale, Vikas D, Kunde. Formulation and evaluation of herbal mouthwash. International Journal of Novel Research and Development. ;2023:653-666. [Google Scholar]
How to Cite This Article
Vancouver
Polpelliwar VG, Pandey KS, Shirbhate TM, Firdous Z, Gaidhane PK, Gaidhane MK. Formulation of mouth rinse from natural plant's leaf extract and evaluation of antibacterial activity [Internet]. Int J Pharm Chem Anal. 2024 [cited 2025 Oct 31];11(2):160-163. Available from: https://doi.org/10.18231/j.ijpca.2024.022
APA
Polpelliwar, V. G., Pandey, K. S., Shirbhate, T. M., Firdous, Z., Gaidhane, P. K., Gaidhane, M. K. (2024). Formulation of mouth rinse from natural plant's leaf extract and evaluation of antibacterial activity. Int J Pharm Chem Anal, 11(2), 160-163. https://doi.org/10.18231/j.ijpca.2024.022
MLA
Polpelliwar, Vinay Gajanan, Pandey, Kavita Shukla, Shirbhate, Trupti Madhukar, Firdous, Zohra, Gaidhane, Pravin Krishnarao, Gaidhane, Mahesh Krishanarao. "Formulation of mouth rinse from natural plant's leaf extract and evaluation of antibacterial activity." Int J Pharm Chem Anal, vol. 11, no. 2, 2024, pp. 160-163. https://doi.org/10.18231/j.ijpca.2024.022
Chicago
Polpelliwar, V. G., Pandey, K. S., Shirbhate, T. M., Firdous, Z., Gaidhane, P. K., Gaidhane, M. K.. "Formulation of mouth rinse from natural plant's leaf extract and evaluation of antibacterial activity." Int J Pharm Chem Anal 11, no. 2 (2024): 160-163. https://doi.org/10.18231/j.ijpca.2024.022